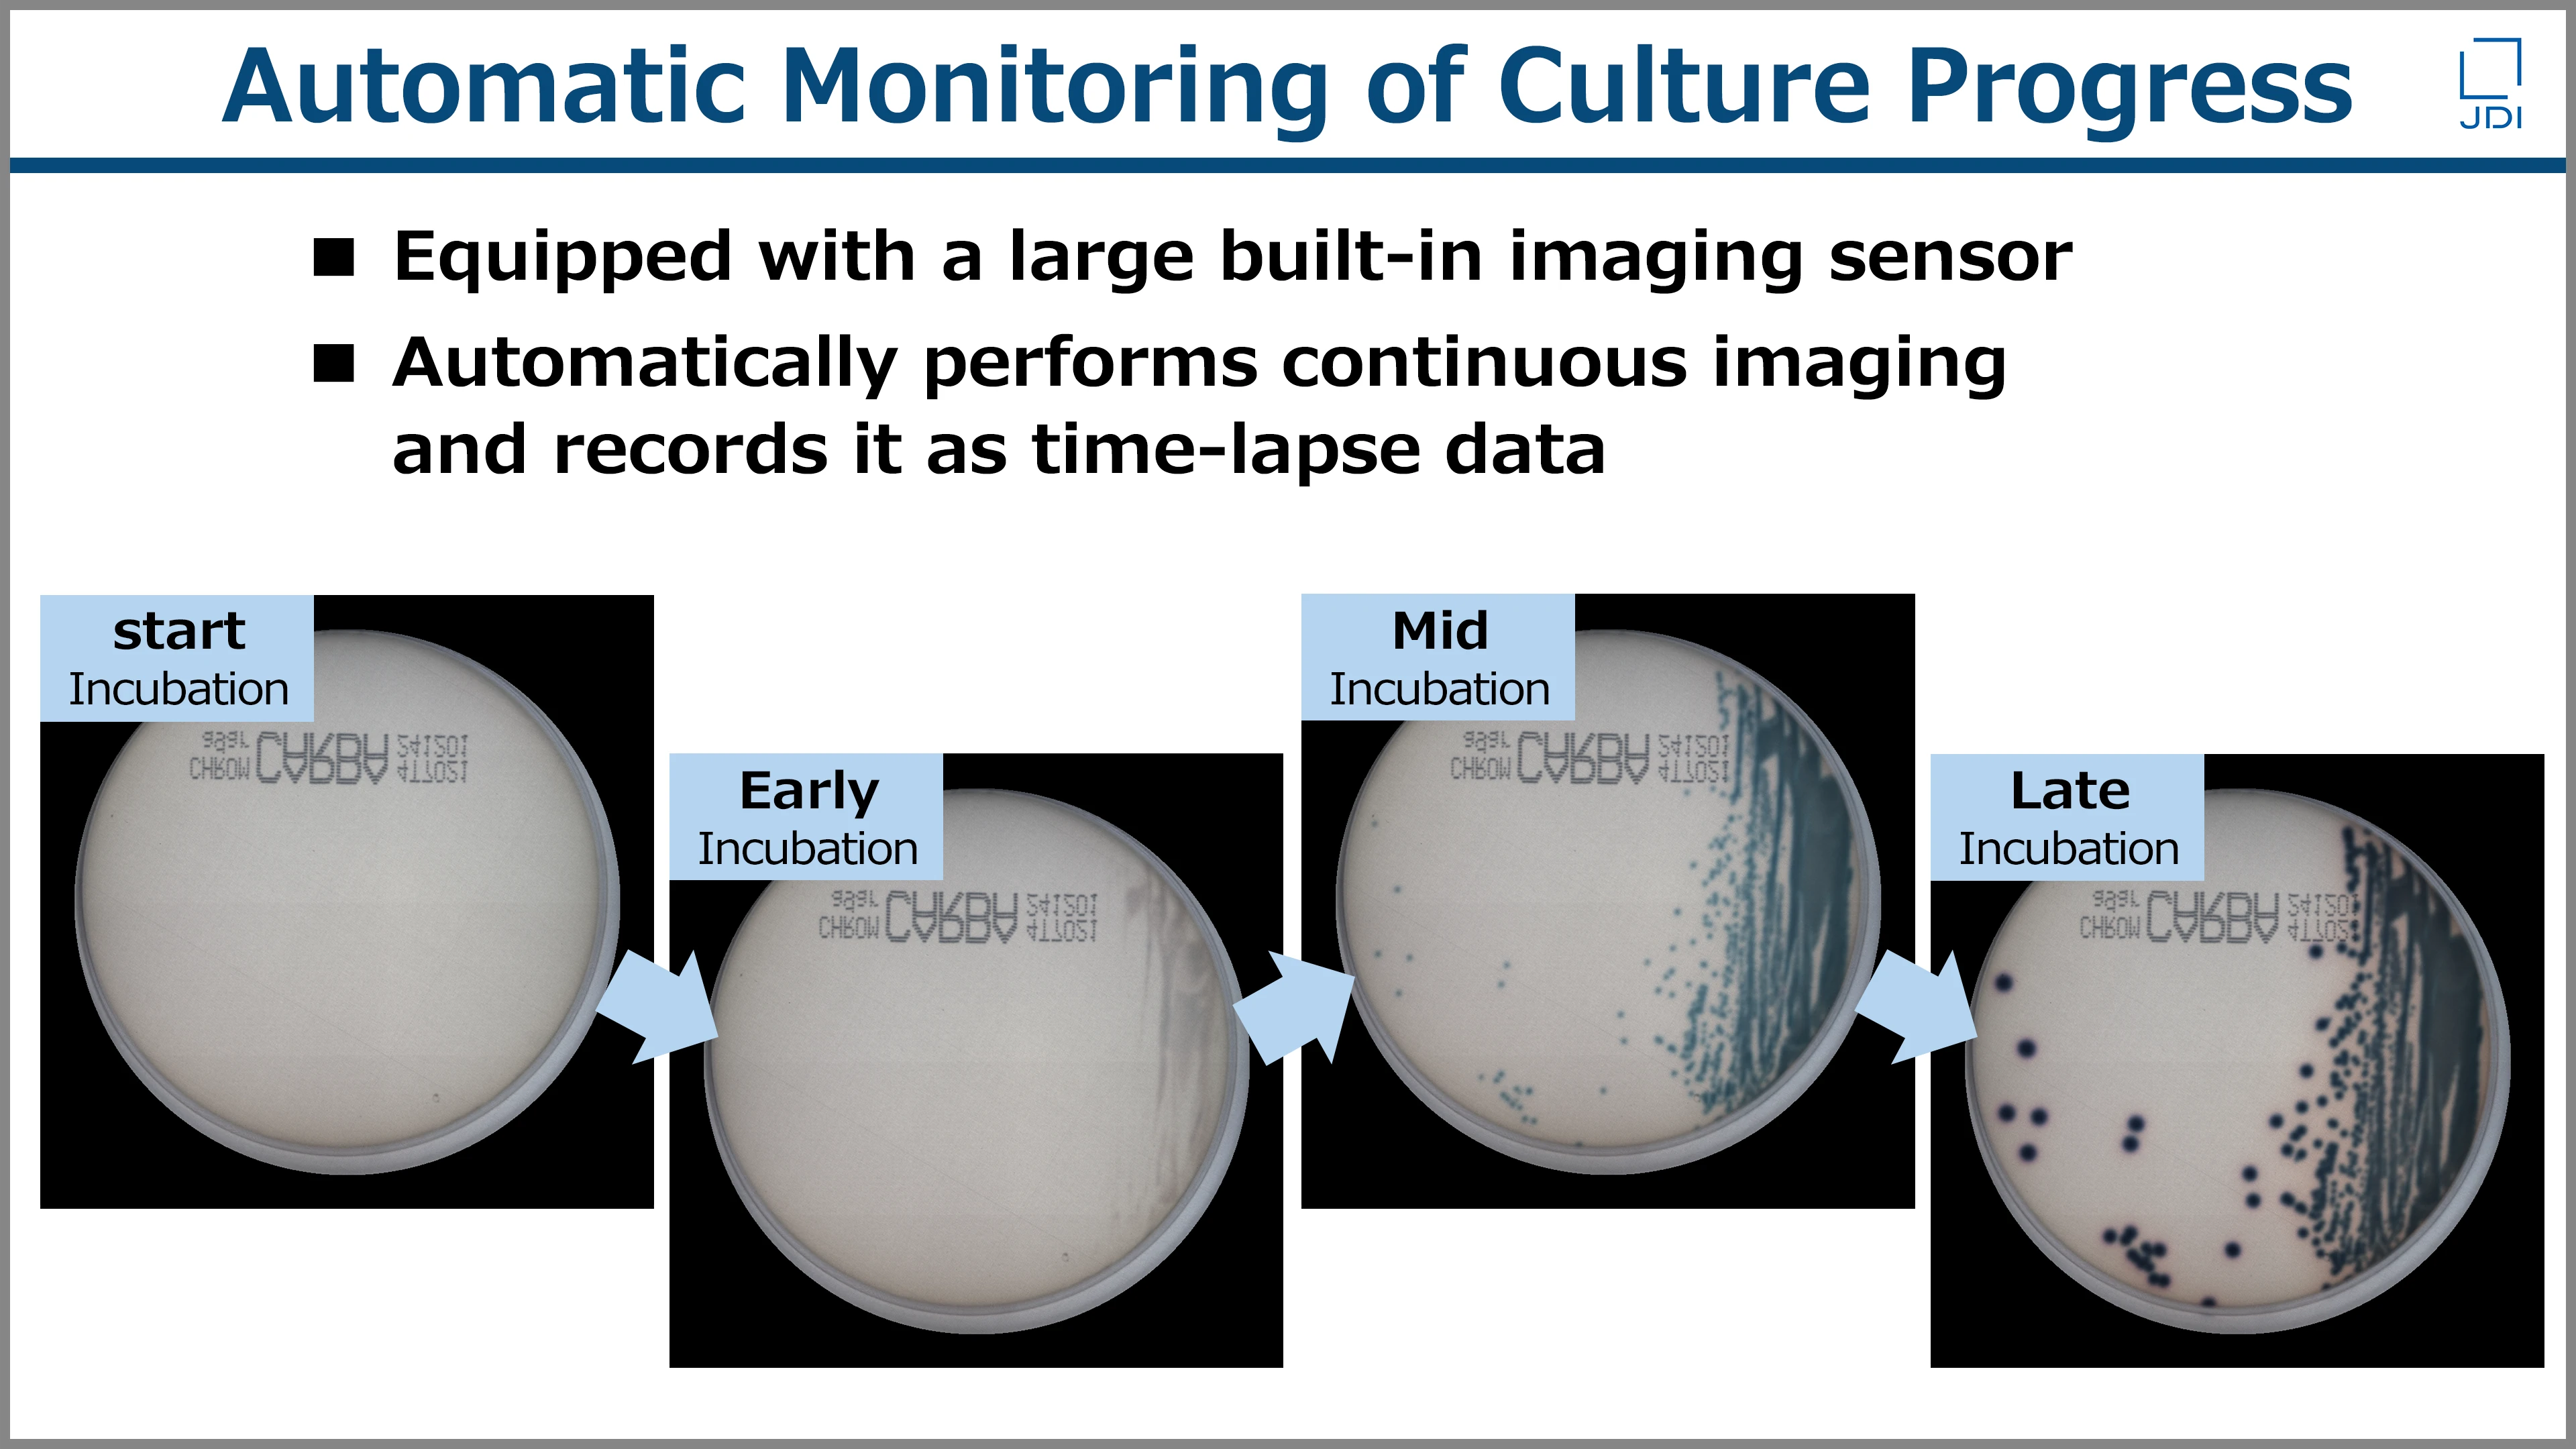

-
SOLTIMO

“Visualizing Changes” in Culture Growth will continue monitoring for you

SOLTIMO is a system that automatically monitors culture growth in real time. It enables continuous acquisition and storage of data that are difficult to obtain through conventional manual observation, and detects subtle changes throughout the growth process with high precision. This is made possible by a large-area 2D imaging sensor based on semiconductor thin‑film deposition technology on glass substrates, developed through Japan Display’s many years of experience in the display industry.
Automatic Time-Lapse Recording of the Growth Process
Using a large-area 2D imaging sensor integrated inside the device, SOLTIMO automatically, accurately, and continuously measures culture growth on solid media. These measurements are recorded as time‑lapse data.
Output of Diverse Data Through Image Analysis
The acquired time‑lapse data are processed using image analysis to output various results and their changes over time.
Examples of output data include:
- Measurement of inhibition zone diameters
- Colony counting
- Colony growth curves

Compact Housing for Stackable Installation
Thanks to its simple and compact design, multiple units can be stacked and installed inside your existing incubators.
SOLTIMO Use Cases
SOLTIMO is applied across a wide range of fields - from R&D in drug discovery, pharmaceuticals, and tissue culture to culture monitoring in food safety and environmental analysis. Enabled by automated, high-frequency observations, SOLTIMO acquires time-lapse data without additional labor, “Visualizing Changes” that were previously too subtle to detect.
Research and Development

Food Safety

Environment Monitoring


SOLTIMO Key Features
You can see how SOLTIMO visualizes growth processes in culture and detects subtle changes by looking at two key capabilities: "Early Detection" and "Measurement of Zone of Inhibition". The video below introduces these culture monitoring technologies. Please take a look.
SOLTIMO Technical Documents
The linked documents are the property of Japan Display, and its usage is in accordance with the terms and conditions of our website.
Download Technical documents from the following link.
SOLTIMO Product Specifications
| Size | W160mm x D240mm x H64mm | |
|---|---|---|
| Weight | 1.05 kg | |
| Power Supply | USB 5V 1.0A | |
| Supported Plates | Up to Φ90 mm Petri dishes | |
| Number Of Measurable Plates | 1 plate / unit | |
| Discs Detectable For Inhibition Zone Measurement | Up to 7 discs | |
| Operating Environment | 5~40℃ (No condensation) *1 | |
| Simultaneous Connections | Up to 10 units can be connected to a single PC *2 | |
| Control App Supported Languages | Japanese / English | |
| Accessories | USB cable, Ethernet cable *3 | |
*1 The unit is intended to be installed inside an incubator.
*2 The PC and the unit are connected via USB and Ethernet cables. When connecting multiple units, a USB hub and an Ethernet hub are also required.
*3 A dedicated control PC (sold separately) is required. When connecting multiple units, a USB hub and an Ethernet hub are also necessary.
SOLTIMO Oeration Manual (Movie)
| Setting up the system |
|---|
| Detection mode |
| Disc diffusion test mode |
| Viewing the log data |
| System shut down |
For enquiries about SOLTIMO, please contact us.